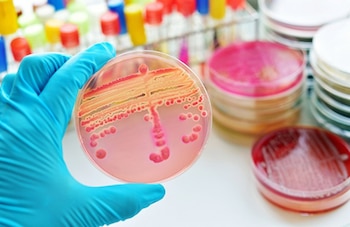

Durante la jornada “¿Estamos preparados para una era post-antibiótica?”, el presidente de la Sociedad Española de Enfermedades Infecciosas y Microbiología Clínica (SEIMC), Javier Membrillo, destacó una estadística que pone en perspectiva la gravedad de las resistencias bacterianas en España: por cada víctima mortal de accidente de tráfico en el país, veinte personas fallecen debido a infecciones ocasionadas por bacterias multirresistentes. En este contexto, se reiteró la petición de creación de la especialidad de enfermedades infecciosas como elemento clave para atajar la crisis que suponen las resistencias antimicrobianas en España.
Según consignó el medio Europa Press, la SEIMC insistió en el Congreso de los Diputados en la necesidad de establecer esta especialidad médica en el sistema de formación sanitaria, considerando que España sigue siendo, en 2026, el único país de Europa que carece de esta figura profesional reconocida. La demanda principal radica en el impacto positivo que demostraron más de una decena de ensayos clínicos, en los que la mortalidad de los pacientes con infecciones complejas disminuyó cuando estos fueron atendidos por especialistas con formación homologada en enfermedades infecciosas. Esta carencia en el sistema de salud español, según consideró Membrillo, debe resolverse a través de un enfoque integral donde colaboren industria, administraciones públicas, profesionales sanitarios de diversas ramas y sociedades científicas, siguiendo la perspectiva ‘One Health’. La SEIMC lleva años reclamando la especialidad, la cual proponen materializar específicamente mediante el sistema de residencia médica (MIR).
A principios de año, el Comité Técnico coordinado por la Dirección General de Ordenación Profesional del Ministerio de Sanidad emitió un dictamen favorable para la creación de la especialidad en enfermedades infecciosas, según publicó Europa Press. En el mismo acto, intervino el presidente de la sección de Enfermedades Infecciosas de la Unión Europea de Médicos Especialistas, Jean-Paul Stahl, quien subrayó la importancia de que España reconozca esta especialidad, argumentando que la resistencia a los antibióticos constituye un problema de escala mundial y que los brotes imprevisibles requieren expertos formados en la materia. "Lo necesitáis, es absolutamente necesario debido al contexto global. La resistencia a los antibióticos es un problema muy grave. Hay brotes inesperados, ¿cómo podemos abordarlos? Creo que los especialistas en enfermedades infecciosas están mejor preparados para esto", expresó Stahl, según el medio. El especialista europeo añadió que estos profesionales ofrecen diagnósticos más precisos, interpretación microbiológica adecuada, tratamientos rápidos y efectivos, y una mejor gestión ante brotes, además de fomentar el uso apropiado de los antibióticos. Stahl concluyó con referencia directa a España afirmando: "Sois el único país en Europa sin una especialidad reconocida (...) Espero de verdad que tengáis éxito (en la creación), lo espero de verdad. Sé que es muy difícil (...) pero tenéis que tener éxito. Es una cuestión de beneficio para la población".
La resistencia antibiótica se mantuvo en el centro del debate durante el encuentro, donde la vicepresidenta de la SEIMC, Patricia Ruiz, realizó un llamamiento a la cooperación entre especialistas, industria farmacéutica, pacientes, instituciones y autoridades políticas, a quienes señaló como responsables de articular las normas que permitan operar eficazmente frente al avance de las resistencias, según detalló Europa Press. Ruiz valoró especialmente el trabajo de la Agencia Española de Medicamentos y Productos Sanitarios (AEMPS) en la elaboración del Plan Nacional frente a la Resistencia a los Antibióticos (PRAN). Este programa fue definido por la vicepresidenta de la SEIMC como un punto de inflexión en la lucha contra la crisis.
Tomando la palabra durante el acto, la directora de la AEMPS, María Jesús Lamas, hizo referencia a la importancia de visibilizar el problema, indicando que existe la necesidad de que la respuesta trascienda el espacio exclusivamente profesional. Lamas explicó que “cada año, se registran unas 35.000 muertes por infecciones hospitalarias causadas por bacterias resistentes en Europa y en torno a 5.000 en España”. Según sus datos, el coste económico de estas resistencias asciende a 1.500 millones de euros por gastos sanitarios adicionales en Europa anualmente, de los que alrededor de 150 millones corresponden a España, como consignó Europa Press.
Lamas destacó que el desarrollo de estrategias nacionales y europeas ha favorecido avances como la reducción, desde 2014, del consumo de antibióticos en salud humana en un 13,5% y en sanidad animal en un 69,5%. Para la responsable de la AEMPS, estos resultados, aportados en el marco del PRAN, demuestran que la dirección política y técnica es efectiva, aunque consideró que resulta imprescindible mantener la vigilancia, fortalecer la investigación, impulsar el uso racional de los antimicrobianos, apoyar la innovación y concentrar las políticas públicas en este desafío sanitario. Lamas subrayó que “la resistencia a los antibióticos no es un problema del futuro, es un desafío urgente del presente, pero aún estamos a tiempo. Los datos son contundentes y también lo son las herramientas para actuar”.
En la jornada, los participantes pusieron en común estrategias a nivel nacional y europeo para consolidar una respuesta coordinada frente al avance de las bacterias resistentes. Según reportó Europa Press, el enfoque ‘One Health’ —que integra la salud humana, animal y medioambiental— fue resaltado como imprescindible para contener la crisis sanitaria por resistencia antimicrobiana. Además, quedó de manifiesto la creciente presión sobre las autoridades y los decisores políticos para aprobar la especialidad de enfermedades infecciosas, reconociendo el valor que supondría para la calidad asistencial y para la protección de la salud pública ante amenazas presentes y futuras.
Últimas Noticias
El Real Oviedo (Grupo Pachuca), galardonado en el norte de España por su campaña 2025
UNCTAD: crisis de fertilizantes por cierre de Ormuz puede afectar a seguridad alimentaria
Israel cerrará los cruces fronterizos de Gaza dos días de la Pascua judía
La tasa de paro de Colombia cae al 9,2% en febrero, 1,1 puntos menos y en mínimos para un febrero desde 2021

Cuatro muertos más en un nuevo ataque israelí en el sur de Líbano
Un bombardeo aéreo en Bint Yebeil deja al menos cuatro fallecidos según medios locales, mientras múltiples localidades del sur sufren nuevos impactos en el marco de la ofensiva, que ya ha provocado más de mil víctimas desde marzo
